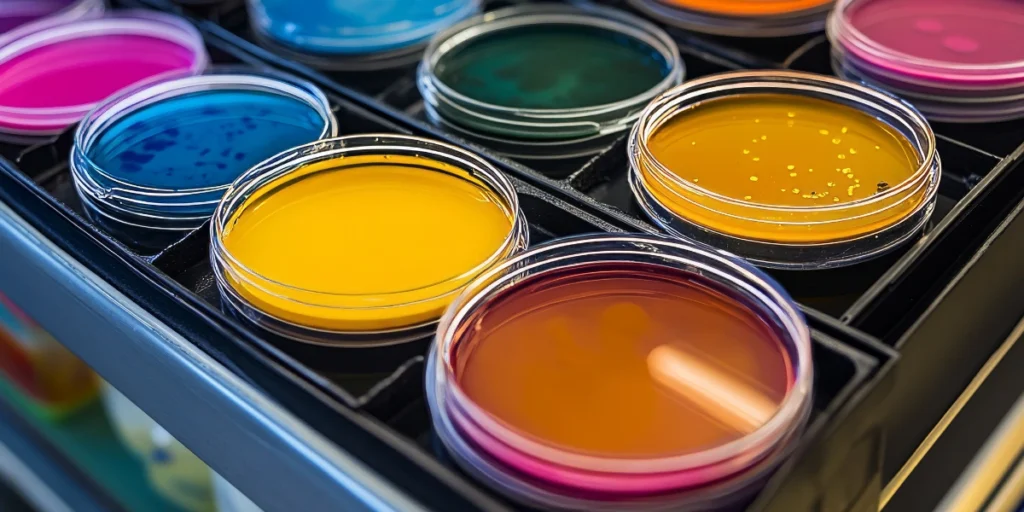
Vibrant liquid chemicals in lab containers showcasing quality control in CPEC Chemical Logistics operations

CPEC Chemical Logistics is becoming increasingly important as global supply chains continue to shift eastward. Western China has emerged as a strategic industrial hub rather than a distant hinterland. Provinces such as Xinjiang, Gansu, and Sichuan are seeing steady growth in chemicals, pharmaceuticals, agrochemicals, and advanced materials.
Yet one challenge remains consistent for exporters and manufacturers alike: moving chemicals safely, efficiently, and cost-effectively into these inland markets.
This is where the China–Pakistan Economic Corridor, or CPEC, becomes a game changer. More than just a network of roads and ports, CPEC is reshaping how chemical supply chains connect South Asia, the Middle East, and Western China.
Why Chemical Logistics into Western China Is Different
Transporting chemicals is never simple. Strict safety regulations, temperature controls, hazardous material classifications, and compliance documentation are non-negotiable. When the destination is Western China, those challenges are amplified by geography.
Traditional routes often rely on long eastern seaboard shipping lines followed by extensive inland transport.
This adds time, cost, and risk, especially for bulk chemicals or time-sensitive inputs used in manufacturing.
Optimising CPEC Chemical Logistics addresses these pain points by shortening distances, reducing handling stages, and creating more predictable transit timelines.
CPEC as a Strategic Trade Corridor
At its core, CPEC links Pakistan’s Gwadar Port with China’s western regions through a modern network of highways, railways, and energy infrastructure. For chemical exporters, this corridor offers an alternative to congested eastern ports and longer maritime routes.
Gwadar’s location near major Middle Eastern shipping lanes allows chemicals sourced from the Gulf, Africa, or South Asia to enter the corridor quickly.
From there, cargo can move northward directly into Western China, bypassing thousands of kilometres of detours.
This shift has significant implications for Western China Trade Routes, particularly for industries that rely on steady inflows of raw and intermediate chemical products.

Improving Cost Efficiency and Transit Time
One of the most immediate benefits of using CPEC for chemical transport is cost optimisation. Shorter routes translate into lower fuel consumption, reduced port handling fees, and fewer transhipment risks.
For example, a shipment of industrial solvents moving from the Middle East to Xinjiang via eastern
Chinese ports may take several weeks longer than a CPEC-enabled route through Gwadar. That time difference impacts working capital, inventory planning, and production schedules.
Companies that integrate CPEC Freight Solutions into their logistics planning often find they can operate leaner inventories while maintaining supply reliability.
Supporting Belt and Road Chemical Trade
CPEC is a flagship component of the broader Belt and Road Initiative, and chemicals play a central role in that vision. From fertilisers and polymers to specialty chemicals used in electronics and renewable energy, cross-border chemical trade is expanding rapidly.
The alignment between CPEC infrastructure and Belt and Road Initiative chemicals trade creates new opportunities for manufacturers and distributors.
Dedicated industrial zones, improved customs coordination, and standardised documentation processes help reduce friction at borders.
Over time, this integration is expected to encourage joint ventures, regional processing hubs, and downstream chemical manufacturing closer to Western China’s industrial centres.
Safety and Compliance Along the Corridor
Chemical logistics is not just about speed and cost. Safety and regulatory compliance are critical, especially when transporting hazardous materials across borders.
CPEC-backed infrastructure has been designed with heavy industrial cargo in mind. Purpose-built highways, upgraded rail links, and controlled logistics zones allow for safer handling of chemical consignments. In addition, customs authorities on both sides are working toward better data sharing and pre-clearance systems.
For businesses involved in Industrial Logistics China, this means fewer delays due to inspections and a clearer compliance pathway from origin to destination.
Real-World Use Case: Industrial Inputs for Western China
Consider a manufacturer in Western China producing construction materials that rely on imported chemical additives.
Previously, inconsistent delivery schedules forced the company to hold excess stock, tying up capital and warehouse space.
By rerouting shipments through CPEC, the company reduced transit time variability and gained better visibility across the supply chain. The result was lower logistics costs, improved production planning, and stronger supplier relationships.
This kind of optimisation is becoming increasingly common as firms gain confidence in CPEC Chemical Logistics and its supporting ecosystem.
Digitalisation and Future Readiness
Another often overlooked advantage of the corridor is its focus on digital logistics. Smart tracking, electronic documentation, and integrated customs platforms are gradually being rolled out along CPEC routes.
For chemical exporters, this improves traceability and risk management. Real-time shipment visibility allows quicker responses to temperature deviations, route disruptions, or regulatory checks.
As these systems mature, CPEC is expected to set a benchmark for cross-border chemical logistics across Asia.
Challenges to Keep in Mind
While the potential is strong, businesses should approach CPEC with informed planning. Route selection, security considerations, insurance coverage, and partner reliability all matter.
Chemical cargo requires specialised carriers and experienced freight handlers familiar with regional regulations.
Working with logistics providers who understand both the corridor and the nuances of chemical transport is essential to fully realise the benefits.
A Smarter Way Forward
Western China’s industrial growth shows no sign of slowing. As demand for chemicals continues to rise, supply chains must evolve to keep pace. CPEC offers more than an alternative route; it provides a strategic framework for building resilient, efficient, and future-ready logistics networks.
For companies willing to adapt, CPEC Chemical Logistics can become a competitive advantage rather than just a transport option.
By aligning infrastructure, compliance, and digital systems, the corridor is helping reshape how chemicals move into one of China’s most important growth regions.
In a world where supply chain efficiency defines market leadership, leveraging CPEC may well be the smartest move chemical businesses make in the decade ahead.





